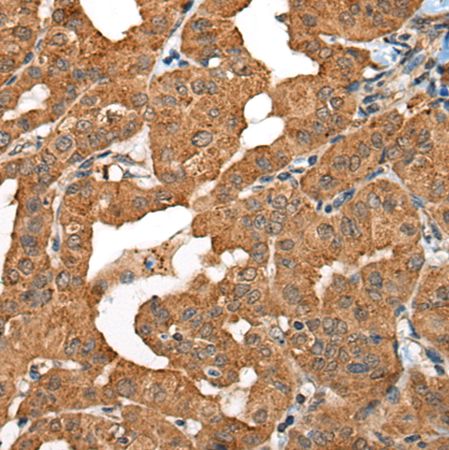
产品封面图

万千商家帮你免费找货
0 人在求购买到急需产品
- 详细信息
- 文献和实验
- 技术资料
- 形态:
液体
- 保存条件:
冷冻(-20℃)避光
- 克隆性:
多克隆
- 保质期:
一年
- 抗原来源:
RMC1
- 库存:
200
- 供应商:
上海酶联生物科技有限公司
- 宿主:
Rabbit
- 应用范围:
仅供科研使用
- 抗体英文名:
Anti-RMC1rabbitpolyclonalantibody
- 抗体名:
兔抗RMC1多克隆抗体
- 规格:
100ul/200ul/25ul
| 规格: | 100ul | 产品价格: | ¥1560.0 |
|---|---|---|---|
| 规格: | 200ul | 产品价格: | ¥2500.0 |
| 规格: | 25ul | 产品价格: | ¥420.0 |
英文名称:Anti-RMC1rabbitpolyclonalantibody
别名:regulatorofMON1-CCZ1;MIC1;Mic-1;WDR98;C18orf
抗原:RMC1
相关类别:一抗
储存:冷冻(-20℃)
宿主:Rabbit
反应种属:Human,Mouse
标记物:Unconjugate
克隆类型:rabbitpolyclonal
技术规格
| Background: | Thisgeneencodesacoloncancerassociatedprotein.[providedbyRefSeq,Jan2013] |
| Applications: | ELISA,IHC |
| Nameofantibody: | RMC1 |
| Immunogen: | FusionproteinofhumanRMC1 |
| Fullname: | regulatorofMON1-CCZ1 |
| Synonyms: | MIC1;Mic-1;WDR98;C18orf8;HsT2591 |
| SwissProt: | Q96DM3 |
| IHCpositivecontrol: | HumancolorectalcancerandHumantonsil |
| IHCRecommenddilution: | 25-100 |
风险提示:丁香通仅作为第三方平台,为商家信息发布提供平台空间。用户咨询产品时请注意保护个人信息及财产安全,合理判断,谨慎选购商品,商家和用户对交易行为负责。对于医疗器械类产品,请先查证核实企业经营资质和医疗器械产品注册证情况。
文献和实验。你的目的蛋白和一抗的关系是什么,这点很重要。分析了这点之后,如果显色时间在1分钟之内,目的带可能是特异带。确信下面的带是特异的,建议换一抗,换其他封闭液。 llh刘丽华 目的蛋白和一抗的关系是什么?我不明白这事什么意思啊,我的目的蛋白RAC1蛋白啊,一抗是兔抗大鼠RAC1多克隆抗体啊! coffeeshine 目的蛋白是在什么宿主细胞里表达的? llh刘丽华 哦,是大鼠平滑肌细胞上表
【公告】丁香通试用中心:10月免费试用装精选(10月18日有更新)
blot显色液 HIV-1P24抗原检测试剂盒 Carrier RNA 免费试用装 兔抗人胱抑素C多克隆抗体 DMEM培养基(高糖) BlotStainer 全自动Blot膜杂交系统 自动原位杂交仪 查看更多试用>> 关注我们 丁香通新浪微博:丁香通 丁香通微信号:biomart
071794 h 货号:CSB-RP071794(A4/C) 兔抗人淀粉样肽 beta A4 蛋白多克隆抗体 货号:CSB-PA07179A0Rb 识别种属:人,小鼠 WB:Mouse heart tissue,Mouse kidney tissue,Mouse lung tissue,293,A549,U251,SH-SY5Y IHC:human kidney
技术资料